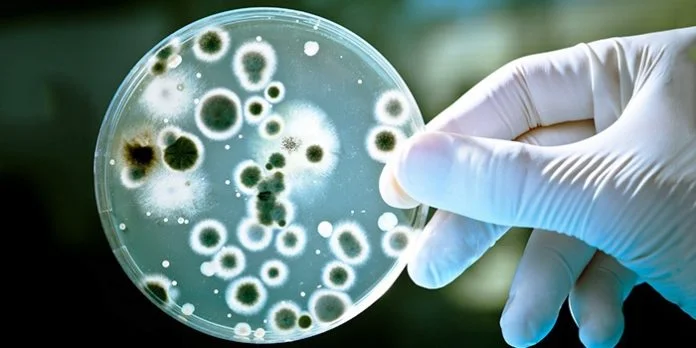

Кольпіт, або вагініт — це захворювання піхви запального характеру, яке викликається патогенною або умовно-патогенною мікрофлорою (стафілококи, стрептококи, гриби роду Candida, кишкова паличка, трихомонади).

Залежно від проходження розрізняють гострий, підгострий і хронічний вагініт. І гострий кольпіт, і хронічний широко поширені серед жінок. Таке захворювання діагностується в 70-80% усіх гінекологічних пацієнток, у тому числі й серед вагітних, дітей, жінок похилого віку. Гострий вагініт (гострий кольпіт) характеризується максимально вираженими клінічними симптомами. Найчастіше діагноз «гострий вагініт» ставлять на першому тижні захворювання, якщо ж воно триває від 2 тижнів до 2 місяців — кажуть про підгострий вагініт. При відсутності лікування гострий кольпіт легко може перейти в хронічний.
Хронічний кольпіт характеризується менш вираженою клінічною симптоматикою й проходить з розвитком рецидивів. У період між рецидивами жінку взагалі може нічого не турбувати, а може змінюватися тільки характер виділень, чому багато хто не надає особливого значення й не поспішає звертатися до лікаря.
Провокують гострий і хронічний вагініт не тільки патогенні бактерії, але й інші чинники:

- Зниження імунітету.
- Порушення гормонального фону.
- Тривалий прийом деяких медикаментів (антибіотики, цитостатики, ГКС).
- Фонові захворювання органів статевої системи.
Якими симптомами проявляється гострий і хронічний вагініт у жінок, як проходить їх лікування — далі в статті.
Хронічний кольпіт: симптоми й лікування
Як проявляє себе хронічний кольпіт? Симптоми цього захворювання в період ремісії досить мізерні. Привертати увагу можуть тільки змінені виділення різної консистенції й часто неприємного запаху.
У фазі загострення приєднуються й інші симптоми:
- Біль, свербіж, відчуття печіння в піхві.
- Хворобливість, дискомфорт унизу живота.
- Дискомфорт і больові відчуття під час статевого акту, сечовипускання.
- Нерідко почервоніння, тріщини зовнішніх статевих органів жінки.
Залежно від того, чим був викликаний хронічний кольпіт, симптоми можуть трохи відрізняться. Отже, якщо причиною вагініту стала трихомонада, то виділення матимуть гнійний характер і жовто-зелений колір, специфічний рибний запах, сильно виражені неприємні відчуття в піхві. Якщо це кандидозний кольпіт хронічний, то виділення матимуть характерну сирнисту консистенцію, білий або жовто-білий колір, трохи кислуватий запах. Вірусний кольпіт характеризується серозно-гнійними або нормальними виділеннями без неприємного запаху і помірно вираженим дискомфортом у піхві.
Хронічний кольпіт, лікування якого не проводиться, або проводиться неналежним чином, загрожує різними ускладненнями. Процес може поширюватися з піхви на матку та придатки, зовнішні статеві органи. При хронічному кольпіті підвищується ризик безпліддя, позаматкової вагітності, зниження лібідо. Отже, як же лікувати хронічний кольпіт? Лікування буде залежати від етіології. Призначаються антибактеріальні (сульфаніламіди, амоксицилін, цефалоспорини), протигрибкові, противірусні препарати і антисептики, наприклад, Флуомізин, Гінофлор. Доцільна й місцева терапія, дієта, зміцнення імунітету.
Гострий вагініт. Лікування кольпіту у жінок
Гострий вагініт, лікування якого було розпочато невчасно, схильний до хронізації. Хронічна форма гірше піддається лікуванню й загрожує серйозними ускладненнями. Вагініт гострий супроводжується такими ж симптомами, як і хронічний, але ці симптоми більш виражені. Отже, як же лікувати гострий вагініт? Лікування, у першу чергу, буде залежати від причини захворювання. Лікування кольпіту в жінок, викликаного бактеріями, обов’язково буде включати антибактеріальні засоби. Якщо хворобу спровокували гриби, доцільні препарати протигрибкової дії (Флюкостат, Дифлюкан, Орунгал), якщо віруси — противірусні. Лікування кольпіту в жінок часто не обходиться без місцевих засобів — вагінальні супозиторії, спринцювання.
Нерідко лікування кольпіту в жінок вимагає й призначення імуностимуляторів (ізопринозин, Генферон). Обов’язковою є дієта з виключенням з раціону гострого, солоного, копченого. На період лікування рекомендується уникати статевих контактів. Також доцільно обстеження й лікування партнера.
